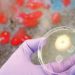

Zeltwanger stellt auf der Control ein neues, preiswertes Basisgerät für die Dichtheitsprüfung vor. ZEDeco ist ein weiteres Mitglied der ZED-Familie und als Einkanalgerät mit sehr schnellen Abtastraten für hochgenaue Messungen konzipiert. Den Auftakt des kom¬pakten und in bewährter Zeltwanger-Qualität gebauten Einkanalgeräts macht das Messver¬fahren Relativdruck. ZEDeco beinhaltet einen OPC-UA-Server und ist damit Industrie 4.0‑fähig. Es kann als Standalone-Gerät verwendet oder mit bis zu drei Geräten pro Ebene im 19“-Rack integriert werden. Das zeitgemäße Design und die Bedienung orientieren sich am Look and Feel moderner Smartphones.
„Unser neues Dichtheitsprüfgerät der ZED-Familie, ZEDeco, überzeugt als preiswertes aber dennoch sehr leistungsstarkes Basisgerät“, betont Andreas Baur, Mitglied der Geschäftsleitung von Zeltwanger Dichtheits- und Funktionsprüfsysteme GmbH. Das neue Einkanal-Basismessgerät erlebt seine Weltpremiere auf der Fachmesse Control. Mit ZEDeco können Anwender hochgenaue Dichtheitsprüfungen mit ultraschnellen Abtastraten durchführen. Auf dem ergonomisch gestalteten Display lassen sich die jeweils wichtigen Messwerte individuell, übersichtlich und leicht ablesbar darstellen. Neben Messdruck, Messergebnis und Fülldruck können beispielsweise auch Korrektur- und Offsetwerte sowie Umgebungsinfos wie Modus, Benutzer, Datum, Uhrzeit und Umgebungstemperatur der Messsituation angezeigt werden. Diagramme und Grafiken verbildlichen den Messprozess bereits während des Prüfablaufs.
Basisgerät für alle Messverfahren und Schnittstellen
Das Premierengerät ZEDeco verfügt über das Relativdruck-Messverfahren, mit dem bereits ein Großteil der Messanforderungen abgedeckt werden kann. Im Jahresverlauf werden die weiteren Verfah¬ren Differenzdruck, Durchfluss und Massenfluss fol¬gen. Dann werden die gesamten Messmöglichkeiten mit dem Medium Luft abgedeckt sein. Anwender wählen so das passende Dichtheitsprüfgerät aus, ohne für nicht genutzte Möglichkeiten bezahlen zu müssen. „Wir wollen mit ZEDeco ins Mengengeschäft für definierte Standardanwendungen einsteigen, oh¬ne Kompromisse bei Qualität und Leistungsfähigkeit der Geräte zu machen“, erklärt Baur. Der Leis-tungsumfang ist dabei beeindruckend. So verfügt das Einkanalgerät über einen OPC-UA-Server und ist damit Industrie 4.0‑fähig. Eine HMI ist auf der Ma¬schinensteuerung integrierbar. Angesteuert werden kann ZEDeco über alle gängigen Schnittstellen wie Profinet, Modbus, OPC-UA, digitale Ein- und Ausgänge oder einen Barcode Scanner.
Das kompakt gebaute Basis-Dichtheitsprüfgerät lässt sich als Standalone-Gerät verwenden. Ebenso kann es – auf Wunsch vieler Anlagenbauer – in ein 19“-Rack integriert werden. Dabei können drei Geräte platzsparend nebeneinander auf einer Ebene platziert werden.
Intuitives Look and Feel moderner Smartphones
ZEDeco ist in bewährter Zeltwanger-Qualität gefer-tigt und in moderner Formensprache gestaltet. Das Display ist ergonomisch und blickwinkelorientiert gestaltet und lässt sich leicht bedienen. Ein zeitge¬mäßes Design und die Bedienung orientieren sich am intuitiv bedienbaren Look and Feel moderner Smartphones.